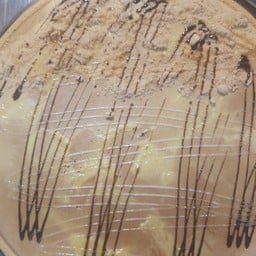
สถานีเครป

- หน้าแรก
/
- ร้านอาหารในอำเภอเมืองอุบลราชธานี
/
- ร้าน ไก่ทอด หนังไก่ทอด ข้าวเหนียว ตลาดดอนกลางซอย2 เกสราแซ่บเวอร์ (Fried Chicken, Fried Chicken Skin, Sticky Rice, Don Klang Market Soi 2, Kesara Saeb Wer)
ไก่ทอด หนังไก่ทอด ข้าวเหนียว ตลาดดอนกลางซอย2 เกสราแซ่บเวอร์OFFICIAL
OFFICIAL
0 เรตติ้ง (0 รีวิว)
อาหารอีสาน/ร้านส้มตำ
ปิดอยู่จะเปิดในเวลา 11:30

777/27, 18 ขามใหญ่ เมืองอุบลราชธานี อุบลราชธานี อุบลราชธานี (ตลาดใหม่ดอนกลาง)
เบอร์โทร : 0815930585
ร้านคล้ายๆ กันที่สมาชิกวงในแนะนำ

Santa Fe Steak (ซานตา เฟ่ สเต๊ก) เซ็นทรัลพลาซา อุบลราชธานี ชั้น 3
3.5
5.1 กม. จากร้านนี้
ร้านอาหารในบริเวณใกล้เคียง
เวลาเปิดร้าน
| ทุกวัน | 11:30 - 21:00 |
- สัตว์เลี้ยงเข้าได้
- รับบัตรเครดิต
- เดลิเวอรี
- เหมาะสำหรับเด็กๆ